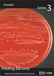

Continue to check our website for further updates on when we will reopen. When the museum reopens, all visitors will need to make reservations at least a week in advance. Walk-in visits are no longer permitted.
Infectious Disease Trading Cards
This card set has photos and information about some of the infectious diseases that CDC studies. You can view the set online OR download and print your own copy. To view or print your own set, you will need Adobe Acrobat Reader. You can download a free copy at https://get.adobe.com/reader/.
Disease Cards by Set
-

Infectious Diseases [PDF 108KB]
Series 1
Learn more about infectious diseases of public health importance. Test your knowledge with quiz on back of card. -

Anthrax [PDF 99KB]
Anthrax is a serious disease caused by a very small organism made up of one cell. -

Avian Influenza [PDF 89KB]
Avian flu (or bird flu) is a disease caused by viruses that occur naturally among wild birds. -

Cryptosporidiosis [PDF 243KB]
Cryptosporidiosis is caused by a parasite so small that about 10,000 of them could fit on the period at the end of this sentence. -

Cyclosporiasis [PDF 81KB]
Cyclosporiasis is a disease caused by Cyclospora, which is a parasite too small to be seen without a microscope. -

Drug Resistance [PDF 80KB]
happens when antimicrobial drugs – some of which are called antibiotics – can no longer kill microbes or stop them from growing. -

Ebola [PDF 78KB]
Ebola hemorrhagic fever is a severe disease caused by a virus. -

E. coli O157:H7 Infection [PDF 83KB]
E. coli is a type of bacteria. In 1982, scientists discovered E. coli O157:H7 could make people very sick. -

Hantavirus [PDF 88KB]
Hantavirus pulmonary syndrome is a deadly disease spread by certain mice and rats. -

HIV [PDF 88KB]
HIV, the virus that causes AIDS, lives in blood, semen, vaginal fluids, and breast milk. -

Legionnaires’ Disease [PDF 81KB]
Legionnaires’ disease is caused by Legionella bacteria. -

Lyme Disease [PDF 88KB]
Lyme disease is spread by the bite of a deer tick. -

Psittacosis [PDF 80KB]
Psittacosis, sometimes called “parrot fever,” is a disease spread from birds to humans. -

Rabies [PDF 88KB]
Rabies is a serious disease caused by a virus. -

Recreational Water Illness [PDF 83KB]
Recreational water illnesses are caused by swimming in water contaminated with germs like Cryptosporidium, Giardia, E. coli O157:H7, and Shigella. -

Salmonellosis [PDF 83KB]
Salmonellosis is caused by a germ called Salmonella. -

SARS [PDF 81KB]
Severe Acute Respiratory Syndrome is caused by a virus that infects the lungs. -

Staph Infection [PDF 74KB]
Staph is one of the most common germs found on people’s skin and in their noses. -

Strep A Infection [PDF 83KB]
Strep A is a type of bacteria often found in the throat or on the skin. -

Tuberculosis [PDF 78KB]
Tuberculosis is caused by bacteria and usually attacks the lungs. -

Ulcers [PDF 75KB]
An ulcer is a sore or hole in the lining of the stomach or the duodenum (first part of small intestine). -

West Nile Virus [PDF 77KB]
West Nile virus is spread by the bite of an infected mosquito.
-

Before Vaccines [PDF 190KB]
Before vaccines, many children died from diseases that vaccines now prevent, such as whooping cough, measles, and polio. -

Chickenpox [PDF 165KB]
Chickenpox is a disease caused by infection with the varicella zoster virus, which causes fever and an itchy rash. -

Diphtheria [PDF 173KB]
Diphtheria is a respiratory diseae caused by bacteria. -

Hepatitis A [PDF 180KB]
Hepatitis A is caused by a virus that causes disease of the liver. -

Hib [PDF 200KB]
Hib is a bacterial disease. Hib is not related to influenza (flu). -

Measles [PDF 188KB]
Measles is a serious disease. Every year, measles still kills over 700,000 people around the world. -

Mumps [PDF 161KB]
Mumps is causes by a virus that spreads from one person to another by coughing, sneezing, or simply talking. -

Pertussis [PDF 181KB]
Pertussis, Whooping cough, is a highly contagious respiratory tract infection. -

Polio [PDF 132KB]
Polio is caused by a virus that lives in throats and intestines. -

Rubella [PDF 182KB]
Rubella is an acute viral disease that causes fever and rash. -

Tetanus [PDF 157KB]
Tetanus (lockjaw) is a serious disease that causes painful tightening of the muscles, usually all over the body. -

Vaccines [PDF 175KB]
Without vaccines, epidemics of many preventable diseases could return, resulting in increased – and unnecessary – illness, disability, and death.
-

Disease Detectives [PDF 150KB]
Disease detectives look at clues from tiny germs to unravel the mystery of disease. -

Foodborne Disease [PDF 156KB]
Foodborne diseases are sometimes caused by tiny bacteria that makes us sick. -

Gathering Evidence [PDF 145KB]
Doctors and nurses gather evidence from sick people to find out if food made them ill. -
Finding Bacteria [PDF 151KB]
Microbiologists play an important role in solving the mystery of disease. -

High-Tech Answers [PDF 139KB]
When microbiologists find disease-causing bacteria, they send them to a laboratory for DNA fingerprinting. These laboratories use high-tech equipment to make DNA fingerprints. -

Bacterial Fingerprints [PDF 131KB]
Each type of bacteria has unique DNA which makes up a pattern of bands called a fingerprint. -

PFGE Patterns [PDF 138KB]
The fingerprints that scientist use to identify bacteria are called Pulsed-Field Gel Electrophoresis (PFGE) Patterns. -

Comparing Fingerprints [PDF 143KB]
After scientist at the public health laboratories have made a bacterial fingerprint, they share pictures of it with the PulseNet team. -

Which Two Match? [PDF 151KB]
Once the PulseNet team has found all the DNA fingerprints that look the same, they make a dendrogram, or bacteria family tree. -

Epidemiologists [PDF 148KB]
If the PulseNet team finds matching bacterial fingerprints from several different patients, they alert the epidemiologists right away. -

Preventing New Cases [PDF 155KB]
Always wash your hands before you eat. -

Campylobacter jejuni [PDF 147KB]
This bacterium hangs out in bird droppings, raw milk, and untreated water. -

E.coli 0157:H7 [PDF 146KB]
You can stop E. coli by never eating raw or undercooked hamburger or by not drinking unpasteurized milk and juice and by always washing your hands after touching raw meats. -

Shigella [PDF 132KB]
Shigella, spreads to other people by contaminated salads, sandwiches, and water. To stop this disease, wash your hands before eating. -

Listeria [PDF 146KB]
Listeria loves cool, wet places like soft cheese, sandwich meat, and hotdogs. Throw away foods that have passed the expiration date and be sure the food you eat is clean and fully cooked. -

Salmonellosis [PDF 149KB]
You can stop Salmonella by eating foods that are clean and fully cooked. Always wash your hands before eating. -

Separate [PDF 158KB]
Some foods have bad germs that can spread to other foods if we are not careful. -

Chill [PDF 139KB]
Be cool. Chill out. Refrigerate promptly. -

Cook [PDF 164KB]
The only way to be sure cooked food is safe to eat is by using a food thermometer. -

Clean [PDF 152KB]
Washing your hands is one of the best ways to kill germs and keep them from spreading.